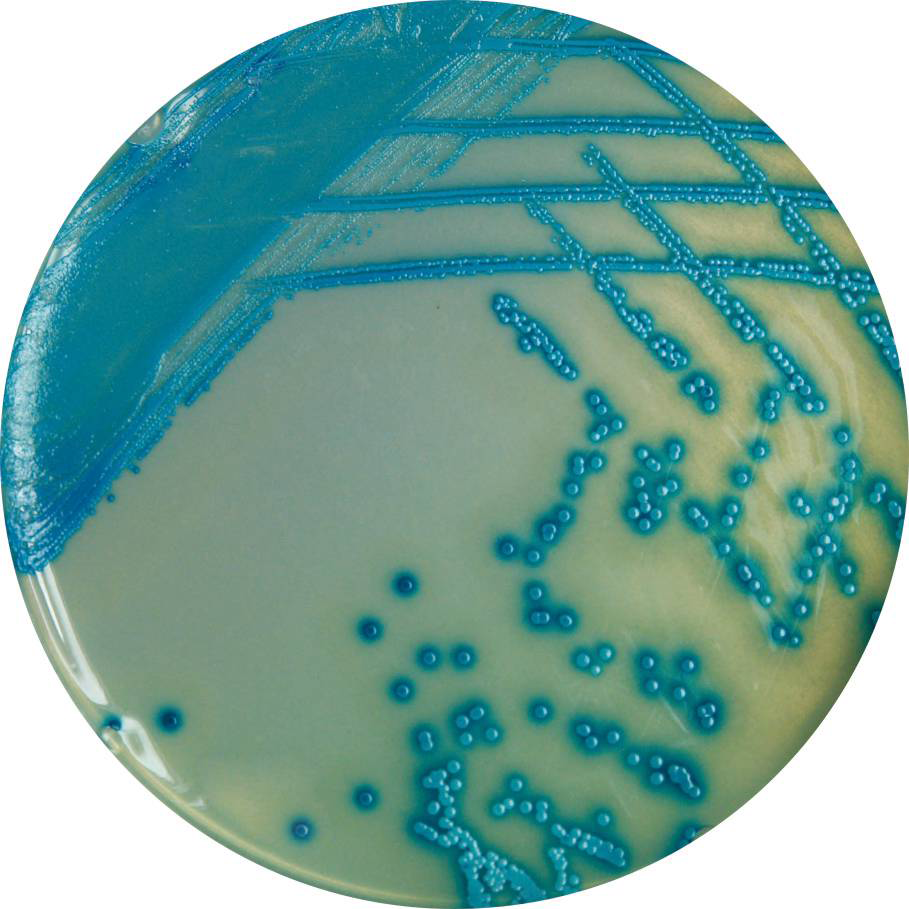

Medii pentru identificarea și diferențierea E.coli și a bacteriilor coliforme (fam. Enterobacteriaceae)
| M1293 | HiCrome™ ECC Agar Diferențierea E.coli și a bacteriilor coliforme |
| M1300 | HiCrome Coliform Agar (cu SLS) Agar selectiv cu laurilsulfat pentru identificarea bacteriilor coliforme și E.coli |
| M1569 | HiCrome Membrane Lauryl Sulphate Agar Agar din laurilsulfat pentru tehnologia membranei (diferențierea și numărarea E.coli și a altor coliforme) |
| M1571 | HiCrome M-TEC Agar Agar pentru identificarea E.coli termorezistente, prin metoda membranei |
| M1574 | HiCrome EC 0157:H7 Agar (Anterior M1298) Identificarea și diferențierea E.coli O157:H7 |
| M1598 | HiCrome Enrichment Broth Base for EC 0157 : H7 Soluție pentru acumularea E.coli 0157: H7 |
| FD230 | HiCrome EC O157:H7 Selective Supplement I Adaos selectiv I EC 0157:H7 |
| M1577 | HiCrome Enterobacter sakazakii Agar Agar cromogen pentru identificarea și izolarea Enterobacter sakazakii |
| M1573 | HiCrome Klebsiella Selective Agar Base Baza HiCrome pentru agarul selectiv pentru identificarea și izolarea Klebsiella |
| M1294 | HiCrome ECC Selective Agar Base Baza agarului selectiv HiCrome ECC pentru identificarea și numărarea E.coli și a bacteriilor coliforme |
| FD190 | HiCrome ECC Selective Supplement Adaos pentru identificarea selectivă a E.coli și coliformelor din apă și produse alimentare |
| M1295 | HiCrome E.coli Agar Agar HICrome pentru identificarea și numărarea E.coli |
| M1340 | HiCrome MacConkey Sorbitol Agar Base Baza agarului HiCrome MacConkey cu sorbitol pentru E.coli enterotoxigene |
| M1575 | HiCrome EC 0157:H7 Selective Agar Base (anterior M1430) Agar selectiv pentru izolarea și diferențierea E.coli O157:H7 (baza) |
| FD187 | HiCrome EC0157:H7 Selective Supplement Adaosul selectiv pentru depistarea rapidă a E.coli 0157:H7 din produsele alimentare |
| M1488 | HiCrome ECD Agar w/MUG Agar ECD pentru identificarea E.coli |
| M1641 | HiCrome Enterobacter sakazakii Agar, Modificat Agar modificat, pentru izolarea și identificarea Enterobacter sakazakii |
| M1816 | HiCrome MM Agar (Modified, HiCrome Miller and Mallinson Agar) Agarul Miller și Mallinson, modificat |
| M1832 | HiCrome Coliform Agar Modified Agarul pentru identificarea E.coli termorezistente |
Medii pentru identificarea Salmonella spp.
| M1296 | HiCrome Salmonella Agar Agar pentru Salmonella |
| M1466 | HiCrome Improved Salmonella Agar Agar pentru Salmonella |
| M1842 | HiCrome Selective Salmonella Agar Base Agar selectiv pentru Salmonella (baza) |
| FD274 | HiCrome Selective Salmonella Agar Supplement Supliment pentru izolarea selective a Salmonella |
| M1633 | HiCrome RajHans Medium Mediul RajHans |
| M1634 | HiCrome RajHans Medium, Modified (Salmonella Agar, Modified Mediul RajHAns, modificat |
Medii pentru izolarea și identificarea Candida spp., drojdiilor și ciupercilor de mucegai
| M1297A | HiCrome Candida Differential Agar Agar selectiv pentru Candida |
| M1297AR | HiCrome Candida Differential Agar, Modified (Base) Baza agarului selectiv pentru Candida, modificat (pentru diferențiere) |
| FD283R | HiCrome Candida Selective Supplement Supliment pentru identificarea rapidă și directă a Candida spp. în cultură mixtă |
| M1467 | HiCrome OGYE Agar Base Baza agarului pentru drojdii și ciuperci |
| M1456A | HiCrome Candida Differential Agar Base, Modified Baza agarului selectiv pentru ciupercile Candida, modificată (pentru diferențiere) |
| FD192 | HiCrome Candida Selective Supplement Supliment pentru identificarea rapidă și directă a Candida spp în cultură mixtă |
Medii pentru izolarea și identificarea Listeria monocytogenes
| M1417 | HiCrome Listeria Agar Base (L.mono Rapid Differential Agar Base)(OTTAVIANI-AGOSTi) Baza agarului pentru identificarea bacteriilor Listeria (test mai rapid) (mediul ALOA,agarul Ottaviani-Agosti) |
| FD181 | HiCrome Listeria Selective Supplement Adaosul selectiv pentru izolarea rapidă și directă a Listeria |
Medii pentru izolarea și identificarea Staphylococcus aureu
| M1468 | HiCrome Aureus Agar Base Baza agarului pentru izolarea și identificarea stafilococilor |
| M1674 | HiCrome MeReSa Agar Base Baza agarului pentru selectarea S.aureus rezistente la meticilină |
| M1837 | HiCrome Staph Agar Base, Modified Agar pentru identificarea stafilococilor (baza), modificat |
Medii pentru izolarea și identificarea Enterococcus spp.
| M1376 | HiCrome Enterococci Broth Soluție pentru enterococci |
| M1580 | HiCrome Ent.faecium Agar Base Agar pentru diferențierea Enterococcus faecium |
| M1830 | HiCrome VRE Agar Base Agar pentru enterococi rezistenți la vancomicină (bază) |
| FD277 | HiCrome VRE Agar supplement Adaosul selectiv pentru baza agarului pentru enterococi rezistenți la vancomicină |
Medii pentru izolarea și identificarea uropatogenilor
| M1353 | HiCrome UTI Agar Agar pentru identificarea și numărarea bacteriilor uropatogene |
| M1418 | HiCrome UTI Agar, Modified Agar pentru identificarea și numărarea bacteriilor uropatogene, modificat |
| M1505 | HiCrome UTI Selective Agar Agar selectiv pentru identificarea și numărarea bacteriilor uropatogene |
Medii pentru izolarea și identificarea altor microorganisme
| M1938R | Leeds Acinetobacter Agar Base (HiCrome Acinetobacter Agar Base) Agarul selectiv pentru izolarea Acinetobacter spp. după Leed (baza) (cromogen) |
| M1651 | HiCrome Bacillus Agar Baza agarului selectiv pentru izolarea și identificarea Bacilus |
| M1682 | HiCrome Vibrio Agar Agar vibrio |
| M1600 | HiCrome Universal Differential Medium Mediul universal pentru diferențiere |
| M1712 | HiCrome Nickels and Leesment Medium Agarul Nickels și Leesment pentru numărarea lacto-bacteriilor |
| M1829 | HiCrome ESBL Agar Base Agar pentru identificarea bacteriilor ce produc beta-lactamaze de spectru larg (baza) |
| FD278 | HiCrome ESBL Agar Supplement Adaos pentru baza agarului pentru identificarea bacteriilor, ce produc beta-lactamaze de spectru larg |
| M1831 | HiCrome KPI Agar Base Agarul pentru bacterii cu sensibilitate redusă la KPI (baza) |
| FD279 | HiCrome KPI Agar Supplement Adaosul pentru baza agarului pentru bacterii cu sensibilitatea redusă la KPI |
| M1840R | Streptococcus Agalactiae Selective Agar Base (HiCrome Strep B Selective Agar Base) Baza agarului selectiv pentru izolarea S. agalactiae (baza agarului selectiv pentru streptococilor din grupa B) |
| FD273 | Hicrome Strep B Selective Supplement Adaosul selectiv pentru streptococii grupei B |
Reviews
There are no reviews yet.